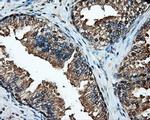
HSPA1A Antibody in Immunohistochemistry (Paraffin) (IHC (P))

Search
OriGene
HSPA1A Monoclonal Antibody (OTI1B2), TrueMAB™
{{$productOrderCtrl.translations['antibody.pdp.commerceCard.promotion.promotions']}}
{{$productOrderCtrl.translations['antibody.pdp.commerceCard.promotion.viewpromo']}}
{{$productOrderCtrl.translations['antibody.pdp.commerceCard.promotion.promocode']}}: {{promo.promoCode}} {{promo.promoTitle}} {{promo.promoDescription}}. {{$productOrderCtrl.translations['antibody.pdp.commerceCard.promotion.learnmore']}}
产品信息
TA500827
种属反应
宿主/亚型
分类
类型
克隆号
抗原
偶联物
形式
浓度
纯化类型
保存液
内含物
保存条件
运输条件
靶标信息
This intronless gene encodes a 70kDa heat shock protein which is a member of the heat shock protein 70 family. In conjuction with other heat shock proteins, this protein stabilizes existing proteins against aggregation and mediates the folding of newly translated proteins in the cytosol and in organelles. It is also involved in the ubiquitin-proteasome pathway through interaction with the AU-rich element RNA-binding protein 1. The gene is located in the major histocompatibility complex class III region, in a cluster with two closely related genes which encode similar proteins.
仅用于科研。不用于诊断过程。未经明确授权不得转售。
篇参考文献 (0)
生物信息学
蛋白别名: dnaK-type molecular chaperone HSP70-1; epididymis secretory protein Li 103; Heat shock 70 kDa protein 1; heat shock 70 kDa protein 1/2; Heat shock 70 kDa protein 1A; heat shock 70 kDa protein 1A/1B; Heat shock 70 kDa protein 1B; Heat shock 70 kDa protein 2; heat shock 70kD protein 1A; heat shock 70kDa protein 1A; Heat shock protein family A member 1A; Heat shock protein family A member 1B; heat shock-induced protein; HSP70-1; HSP70-1/HSP70-2; HSP70-2; HSP70.1/HSP70.2
基因别名: HEL-S-103; HSP70-1; HSP70-1A; HSP70.1; HSP70I; HSP72; HSPA1; HSPA1A; HSPA1B; HSX70
UniProt ID: (Human) P0DMV8
Entrez Gene ID: (Human) 3303